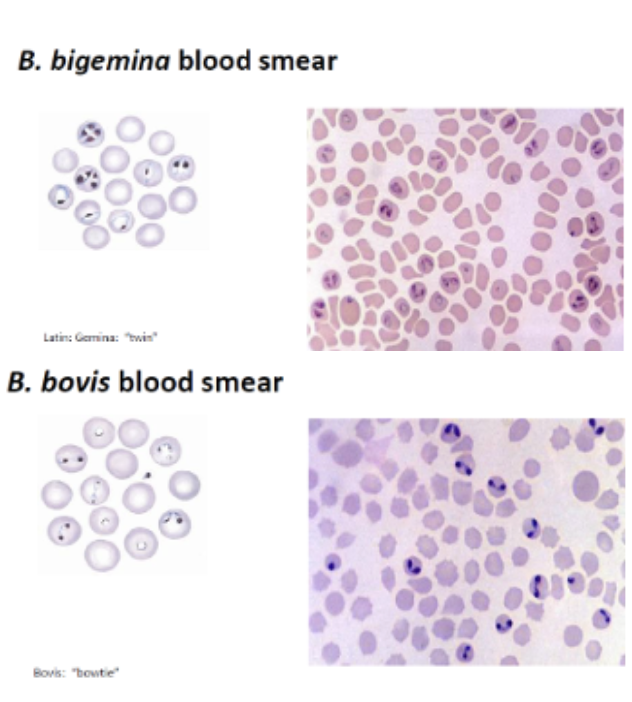
<p><span style="font-family: Calibri, sans-serif;"><span>- </span></span>Anaemia, haemoglobinuria, jaundice</p><p class="MsoListParagraphCxSpMiddle"><span style="font-family: Calibri, sans-serif;"><span>- </span></span>Diarrhoea</p><p class="MsoListParagraphCxSpMiddle"><span style="font-family: Calibri, sans-serif;"><span>- </span></span>Cerebral babesiosis (hyperaesth, aggr, coma, convulsion, paralysis)</p><p class="MsoListParagraphCxSpMiddle"><span style="font-family: Calibri, sans-serif;"><span>- </span></span>Clinpath: anaemia, 5g/L haemoglobinaemia, proteinuria</p><p class="MsoListParagraphCxSpLast"><span style="font-family: Calibri, sans-serif;"><span>- </span></span>PM: organs swollen, congested, anaemic, jaundiced, thin blood, enlarged spleen, enlarged liver, brain grey matter characteristic pink, dilated brain capillaries, watery blood</p><p class="MsoListParagraphCxSpLast"></p><p class="MsoListParagraphCxSpLast"><span style="font-family: Calibri, sans-serif;"><span>- </span></span>Dx: Giema stain</p><p class="MsoListParagraphCxSpLast"><span style="font-family: Calibri, sans-serif;"><span>- </span></span>Tx: Imidocarb</p>
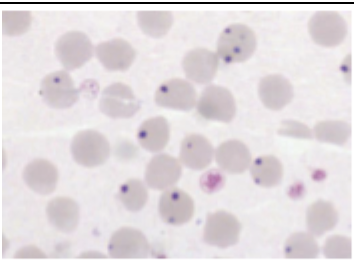
<p>What is this parasite</p>

1/15
Looks like no tags are added yet.
Name | Mastery | Learn | Test | Matching | Spaced | Call with Kai |
|---|
No analytics yet
Send a link to your students to track their progress

What is this parasite
Rhipicephalus australis (cattle tick)
- Damage to hides, decr production
- Anaemia
- Tick worry
Transmission of Babesia/Anaplasma
Tx: SP, amitraz, ML, Acatak


What is this parasite
Haemaphysalis longicornis (bush tick)
Anaemia, decr condition, weakness

What is this parasite
- Anaemia, haemoglobinuria, jaundice
- Diarrhoea
- Cerebral babesiosis (hyperaesth, aggr, coma, convulsion, paralysis)
- Clinpath: anaemia, 5g/L haemoglobinaemia, proteinuria
- PM: organs swollen, congested, anaemic, jaundiced, thin blood, enlarged spleen, enlarged liver, brain grey matter characteristic pink, dilated brain capillaries, watery blood
- Dx: Giema stain
- Tx: Imidocarb

What is this parasite
Anaplasma Marginale
- Fever, depression, inappetence, anaemia, jaundice, weakness, mm tremor
- Appear 1 mos after exposure
- Both taurus and indicus are suscept
- More in animals >1-2yo
PM: anaemia, watery blood, jaundice, spleen/liver enlarged


What is this parasite
Theileria orientalis | - Comma/rod-shaped P in RBC |
Lymphocyte destruction
Leukopenia, anaemia
NO haemolobinuria
Dx: Exclusion, blood smears
Tx: Oxytetracycline, imidocarb

What is this parasite
Linognathus vituli
Alopecia, Anaemia

What is this parasite
Haematobia exigua (buffalo fly)
- Esp withers, shoulders, flanks
Tx: SP, diazinon, ML


What is this parasite
Ostertagia ostertagi
- Reddish brown, may have vulvular flap
- Male spicules are relatively short, divided distally into 2/3 process
- Type 1 (spring) vs Type 2 (autumn)
- Anorex, watery diarr, wt loss, anaemia, hypoalbuminaemia, bottle jaw
- Incr blood pepsinogen


What is this parasite
Bunostomum phlebotum |
- Anaemia, weakness, anorexia, black scour/diarr, wt loss, bottle jaw
- Esp dairy calves 5-12 mos old
PM: intestinal mucosa becomes inflamed & thickened with punctiform haemorr and haemorr enteritis


What is this parasite
Oesophagostomum radiatum
- Anorexia, intermitt diarr, illthrift, emaciation
- L4 feed on small plugs of tissue small intestinal mucosa ulcers


What is this parasite
Paramphistomes ichikawai
- Feed on tissue/blood
- Posterior sucker causes vlli trauma
- Anorexia, polydipsia, wt loss, fluid/foul diarr, dehydrated, weakness, anaemia, bottlejaw death
- PM: oedema, congestive enteritis, erosion, petechiae, villi atrophy, mature in rumen, reticulum
Dx: CS, hx
Tx: Nilzan


What is this parasite
Monieza expansa/benedeni
- 3-5m long
- Scolex with 4 suckers
Diarr, constip, neuro sns, anaemia, wt loss
Dx: eggs in poo
Tx: praziquantel


What is this parasite
Eimeria bovis/zurnii
Severe diarr, dehydration, anaemia, wt loss, anorexia, weakness, tenesmus, rectal prolapse, perineum, tail stained with faeces
- PM: congested intestinal mucosa, catarrhal enteritis, petechial haemorr
Dx: oocysts in diarrhoea
Tx: toltrazuril (tx all)


What is this parasite
Cryptosporidium parvum
Small oocysts, have 4 sporozoites
- Zoonotic
- Severe diarr, severe dehydration, pale yellow diarr with mucous, lethargy anorex, death
Dx: oocysts in poo
Tx: halofuginone

What is this parasite
Dictyocaulus viviparous
- Brown, bent spicules
Tachypnoea, dyspnea, dry cough, ‘air hunger’, wt loss
Dx: CS, hx
Tx: BZD, leva, ML


What is this parasite
Trichomonas foetus
- Pyriform shape
- 4 flagella (3 anterior, 1 posterior)
- Males are asymp carriers
Vaginitis, endometritis, abortions
Dx: CS, wet prep
Tx: 5-nitroimidazole
